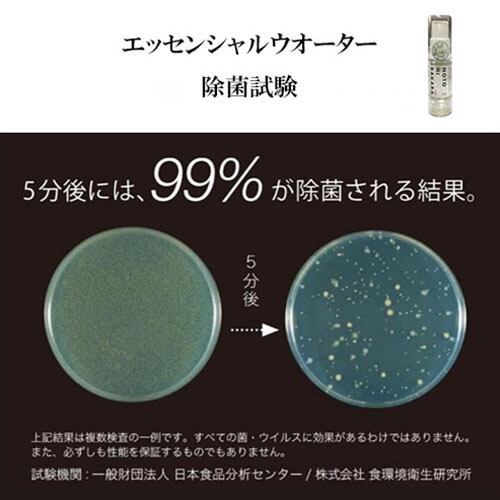

1/12
除菌スプレー&マスクセット(2枚)
¥1,320 税込
別途送料がかかります。送料を確認する
¥10,000以上のご注文で国内送料が無料になります。
【除菌スプレー&マスクセット(2枚)】
マスク生活が日常になった今だからこそおススメです。
除菌・除ウイルス・消臭エッセンシャルウォーターをスプレーして能登ヒバの心地よい香りで気分をリフレッシュしてください。
〈3D立体マスク〉
立体形状が顔のラインにぴったりフィットし、隙間なく着用できるので、花粉や飛沫を防ぎます。軽く丈夫なポリエステル製で、耳が痛くなりにくいマスクです。洗って繰り返しお使いいただけます。
〈除菌・除ウイルス・消臭エッセンシャルウォーター 5ml〉
独自製法によって生まれた天然成分100%の製品。インフルエンザウイルス、黄色ブドウ球菌、アンモニア、大腸菌などに効果が期待できます。能登ヒバの心地よい香りと、自然由来の確かな除菌・除ウイルス・消臭作用がマスク習慣を快適にします。容器は逆さまでもスプレーできる真空ボトルを使用。
製造元 : 加賀木材株式会社
このショップでは酒類を取り扱っています。20歳未満の者の飲酒は法律で禁止されています。
-
レビュー
(39)
-
送料・配送方法について
-
お支払い方法について
最近チェックした商品
同じカテゴリの商品
その他の商品